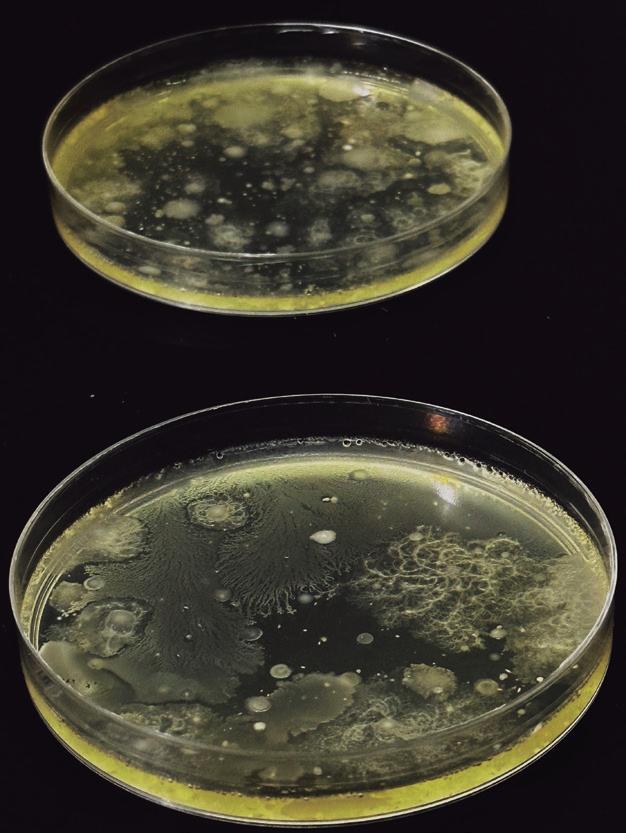
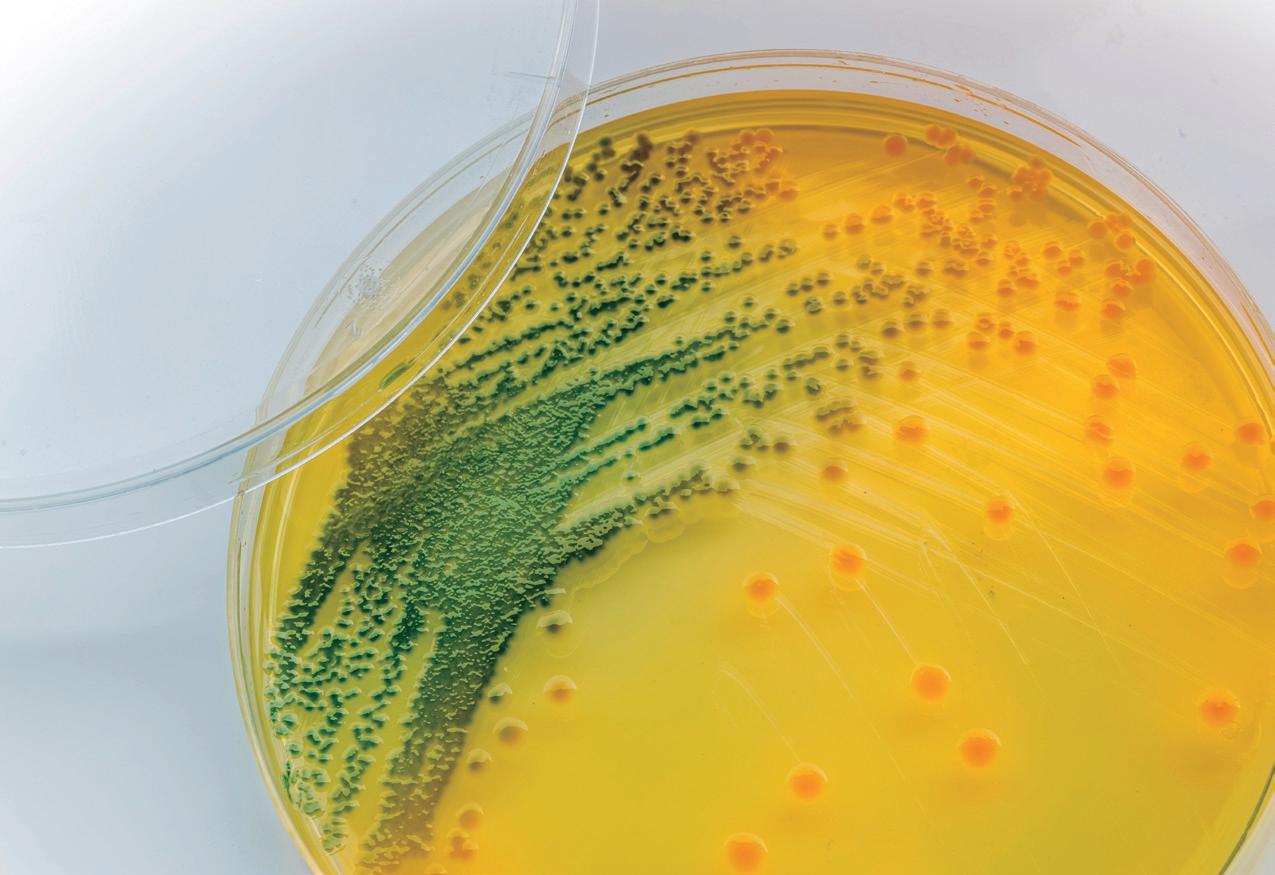

![]()
























Análisis del transcriptoma del ARNm y ARN circular revelan que la suplementación dietética con Lactiplantibacillusplantarum liofilizado estimula la memoria inmunitaria del camarón blanco del Pacífico (Penaeusvannamei) contra agentes patógenos. 06
DIRECTOR Salvador Meza info@dpinternationalinc.com
EDITOR ASOCIADO Marco Linné Unzueta
COORDINADORA EDITORIAL
Karelys Osta edicion@dpinternationalinc.com
DIRECCIÓN ADMINISTRATIVA Adriana Zayas Amezcua administracion@dpinternationalinc.com
COORDINACIÓN DE OPERACIONES Johana Freire opm@dpinternationalinc.com
COLABORADORES EDITORIALES
Carlos Rangel Dávalos
DISEÑO EDITORIAL / PUBLICITARIO Perla Neri / Rozana Bentos design@dpinternationalinc.com
VENTAS Y MARKETING crm@dpinternationalinc.com
CIRCULACIÓN Y SUSCRIPCIONES Renée Meza suscripciones@panoramaacuicola.com
OFICINA EN LATINOAMÉRICA
Empresarios No. #135 No. Int. Piso 7 Oficina 723, Col. Puerta de Hierro, C.P. 45116 Zapopan, Jal., México. Cruza con las calles Av. Paseo Royal Country y Blvrd. Puerta de Hierro Tels: +(33) 8000 0578
OFICINA EN ESTADOS UNIDOS DP INTERNATIONAL INC. 401 E Sonterra Blvd. Sté. 375 San Antonio, TX. 78258 info@dpintertnatinonalinc.com
COSTO DE SUSCRIPCIÓN ANUAL $750.00 M.N. DENTRO DE MÉXICO USD $100.00 EE.UU., CENTRO Y SUDAMÉRICA €80 EUROPA Y RESTO DEL MUNDO (SEIS NÚMEROS POR UN AÑO)
PANORAMA ACUÍCOLA MAGAZINE, Año 30, No. 2, enero - febrero 2025, es una publicación bimestral editada y distribuída por Design Publications, S.A. de C.V. Av. Empresarios #135 Piso 07 Oficina 723 Col. Puerta de Hierro CP. 45116. Zapopan, Jalisco, México. Tel: +52 (33) 80 00 05 78, www.panoramaacuicola.com, info@dpinternationalinc.com. Editor
Responsable: Salvador Antonio Meza García. Número de Reserva de Derechos de Uso Exclusivo 04-2019071712292400-01, licitud de Título No. 12732, Licitud de Contenido No. 10304, ambos otorgados por la Comisión Calificadora de Publicaciones y Revistas Ilustradas de la Secretaría de Gobernación. Permiso SEPOMEX No. PP-14-0033. Impresa por Negocios Gráficos Grafinpren S.A. Teléfono: 04-2221362 ext 28 / 0959537917. Av. C.J. Arosemena Km 2.5 Antiguo Coliseo Granasa, Guayaquil, Ecuador. Este número se terminó de imprimir el 31 de enero de 2025 con un tiraje de 3,000 ejemplares. La información, opinión y análisis contenidos en esta publicación son responsabilidad de los autores y no reflejan necesariamente el criterio de esta editorial. Queda estrictamente prohibida la reproducción total o parcial de los contenidos e imágenes de la publicación sin previa autorización de Design Publications, S.A. de C.V.
Tiraje y distribución certificados por Lloyd International
Visite nuestra página web: www.panoramaacuicola.com

También síganos en:
18 28 32 34 22
Artículo de fondo
Fortaleciendo cadenas de valor: Misión Técnica de Peces Marinos y su impacto ambiental
Artículo
Copépodos Frozen Ocean®: 100% natural y esterilizado con irradiación gamma
Artículo
Efectos de dietas formuladas con diferentes combinaciones de ingredientes alternativos para alimentos sobre el crecimiento, la digestibilidad aparente, las enzimas digestivas y las actividades de expresión génica del camarón blanco del Pacífico, Penaeus vannamei
Artículo
Uso de Biodigester y su impacto positivo durante el proceso de cultivo en los laboratorios de larvas
Artículo
En septiembre, Lima será sede del evento pesquero, acuícola y seafood más importante de la región
Opinión
Ciencia aplicada: innovar contra la corriente






Novedades desde Singapur
Uso y abuso de antibióticos en la cría de camarones
Actores y destino de la inversión en la acuicultura global
¿Qué retos tiene el punto de venta?
Proteínas alternativas para un futuro sostenible: el papel de los grillos y las soldier fly en la seguridad alimentaria global
Avances en acuicultura: comparando la Tecnología Biofloc y la Tecnología Simbiótica

Cerrando ciclos 2024 y con grandes expectativas para 2025, la acuicultura se está transformando día con día y generando grandes oportunidades. También grandes retos, cambios y sobre todo buscando la sustentabilidad en la producción de proteína acuícola, apoyada bajo criterios y principios encaminados al Bienestar Animal y, claro está, con un enfoque integral que garantice el crecimiento, sostenibilidad y calidad de los productos que se ofrecerán al consumidor.
Uno de los puntos críticos de atención ante lo expuesto, y en la tesitura de trabajar con las estrategias para reducir las emisiones de gases de efecto invernadero, en las dietas actuales y futuras, se promueven, en la mayoría de los casos, dietas “verdes” basadas en fuentes de origen vegetal; para lo anterior se deberán establecer estrategias que promuevan el crecimiento, programación y estandarización de la producción, sin dejar de lado el incremento en la rentabilidad y favorecer el aprovechamiento sustentable de los recursos; reflejándose en acciones que permitan la reducción de las emisiones, adoptando tecnologías eficientes en combustible y trabajar en la producción de orga-
nismos acuáticos, con fuentes alternas para la fabricación de alimentos “amigables” con el medio ambiente. Adicionalmente, y atendiendo el principio básico que rige la acuicultura, el desarrollo depende del conocimiento biotecnológico de la especie a manejar y del ambiente en el cual se lleva a cabo el cultivo, así como en la estrategia del uso de alimentos “amigables”, por lo que se debe considerar la I+D+i como una estrategia continua en el desarrollo acuícola, mencionando en particular la experiencia de sistemas de recirculación para la acuicultura (RAS, por sus siglas en inglés), aunado al manejo y niveles de producción intensivos, sistemas que, por múltiples razones como temas de sustentabilidad, eficiencia en consumo de agua-espacio, y la creciente demanda de pescado de los mercados, fue retomado en los últimos años y evaluado en diferentes entornos comerciales con muy buenos resultados.
Por último, es importante considerar que en los logros y alcances obtenidos a estas fechas en el fortalecimiento y desarrollo de la acuicultura a nivel mundial, no debe obviarse la Colaboración, Capacidad Resiliente, Capital de Inversión, entre otros, tomando en cuenta
que, en este nuevo ciclo que inicia, se tienen las herramientas e inversiones necesarias para la innovación en acuicultura, con el apoyo de la producción de calidad a través de la producción bajo estándares de prácticas sostenibles que permiten el desarrollo de estrategias sustentables a inmediato plazo, en donde se incluya la robótica (IA), nanotecnología, biofortificación, cultivos verticales y más, en donde se deberá de privilegiar:
3 La promoción de proyectos estratégicos de alcance sectorial, que permitan la consolidación de la industria acuícola mediante el avance del conocimiento multidisciplinario, orientados a desarrollar tecnologías para especies con potencial de cultivo.
3 El fomento de la vinculación con los sectores productivos para el aprovechamiento de innovaciones tecnológicas en las áreas de acuicultura y biotecnología.
3 La propuesta de nuevos modelos de desarrollo sostenible de la acuicultura marina y dulceacuícola para incrementar y diversificar la producción regional.
Editor Asociado Marco Linné Unzueta


Análisis
del transcriptoma del ARNm y ARN circular revelan que la suplementación dietética con Lactiplantibacillusplantarum
liofilizado
estimula la memoria inmunitaria del camarón blanco del Pacífico
(Penaeusvannamei) contra agentes patógenos
La acuicultura del camarón se enfrenta a importantes desafíos derivados de enfermedades bacterianas y virales, como la necrosis hepatopancreática aguda (AHPND, por sus siglas en inglés) y el virus del síndrome de la mancha blanca (WSSV). Investigaciones recientes destacan el potencial de Lactiplantibacillusplantarum (FD-LAB) como inmunoestimulante dietético para mejorar la inmunidad del camarón. El análisis del transcriptoma reveló que la suplementación con FD-LAB modula los genes relacionados con la inmunidad y los ARN circulares (circARN), lo que potencia la memoria inmunitaria y la resistencia a patógenos.
La acuicultura del camarón desempeña un papel crucial en la seguridad alimentaria mundial, pero se enfrenta a importantes retos, sobre todo debido a las enfermedades que causan graves pérdidas económicas, especialmente en Asia. Entre las principales enfermedades figuran infecciones bacterianas como la necrosis hepatopancreática aguda (AHPND, por sus siglas en inglés) y amenazas virales como
el virus del síndrome de la mancha blanca (WSSV). Debido a su falta de inmunidad adaptativa, los camarones dependen de las respuestas inmunitarias innatas para combatir los patógenos. Con el fin de mejorar su inmunidad, esta investigación se centra en los inmunoestimulantes, que aumentan su resistencia a las enfermedades. Entre ellos, hay compuestos sintéticos y sustancias derivadas de plantas, hongos y bacterias. Las bacterias lácticas (LAB, por sus siglas en inglés), como Lactiplantibacillus plantarum, se usan ampliamente en la acuicultura del camarón como inmunoestimulantes dietéticos. Los estudios han demostrado que la suplementación con LAB mejora el crecimiento, la composición del microbioma intestinal y las respuestas inmunitarias en Penaeus vannamei, lo que aumenta las tasas de supervivencia frente a las infecciones.
Para mejorar la inmunidad del camarón, la investigación se centra en los inmunoestimulantes, que aumentan su resistencia a las enfermedades. Entre ellos figuran compuestos sintéticos y sustancias derivadas de plantas, hongos y bacterias.
Los avances en el análisis del transcriptoma han profundizado la comprensión acerca de la inmunidad del camarón, incluidas las respuestas inmunitarias a la AHPND y el WSSV. Además, los ARN no codificantes, como los ARN circulares (circARN), regulan la expresión génica inmunitaria. Sin embargo, los efectos de la inmunoestimulación sobre la expresión de circARN no se han estudiado lo suficiente.
La “inmunidad entrenada”, un concepto reciente en la inmunidad de los crustáceos, sugiere que la exposición a inmunoestimulantes como L. plantarum liofilizado (FD-LAB, por sus siglas en inglés) puede aumentar la memoria inmunitaria en P. vannamei, mejorando la resistencia a infecciones secundarias. Este artículo resume los resultados de una investigación acerca del potencial de FD-LAB para desarrollar la inmunidad del camarón blanco del Pacífico.
9 Camarón y preparación del alimento: los juveniles de P. vannamei (0.87 ± 0.24 g) se dividieron en grupos de control y FD-LAB, y se aclimataron durante siete días. El alimento se suplementó con L. plantarum liofilizado (FD-LAB) a una concentración de 34.2 mg/g. Los camarones se cultivaron en tanques de recirculación con monitoreo del agua y se alimentaron tres veces al día durante 8 o 15 días.
9 Extracción de ARN y secuenciación: se extrajo el ARN total de los tejidos de las branquias y el estómago de los camarones y se evaluó su calidad. Para la preparación de la biblioteca se empleó el kit Illumina
Stranded mRNA Prep y, posteriormente, se llevó a cabo la secuenciación en una plataforma Illumina MiSeq
9 Análisis del transcriptoma y del circARN: el control de calidad y el análisis de la expresión diferencial se reali-
zaron empleando herramientas bioinformáticas como STAR, RSEM y DESeq2. La detección de circARN se llevó a cabo utilizando el CIRIquant pipeline.
9 Validación qPCR: los genes expresados diferencialmente (DEG, por sus siglas en inglés) y los circARN se validaron mediante qPCR. El ARN se transcribió inversamente y se amplificó empleando “primers” específicos.
9 Pruebas de desafío bacteriano y viral: los camarones fueron expuestos por inmersión a Vibrio parahaemolyticus (AHPND) o WSSV. Se analizaron las tasas de supervivencia mediante el método de KaplanMeier, incluyendo pruebas adicionales de inmunidad entrenada.
Resumendelacalidadyla secuenciación del ARN
Se realizó la secuenciación del ARN en muestras de branquias y estómago de camarón blanco del Pacífico tras 8 y 15 días de alimentación con FD-LAB o con alimento de control.
La secuenciación generó aproximadamente 180 millones de lecturas de alta calidad (Q>30), lo que permitió realizar análisis posteriores fiables.
Perfildeltranscriptomay cambiosenlaexpresióngénica
La suplementación con FD-LAB produjo una expresión génica diferencial (DEG):
9 En el estómago se observaron 14 DEG (8 días) y 22 DEG (15 días), y en las branquias, 80 DEG (8 días) y 40 DEG (15 días) (Figura 1).
La suplementación dietética con Lactiplantibacillusplantarum (FD-LAB) indujo cambios transcriptómicos significativos en Penaeus vannamei, sobre todo en genes relacionados con la inmunidad y la memoria inmunitaria.
9 El estómago presentó 14 DEG (8 días) y 22 DEG (15 días).
9 Se reguló al alza a 17 genes y a la baja a 103.
9 Los DEG incluían genes relacionados con el sistema inmunitario implicados en el reconocimiento de patógenos, la respuesta antimicrobiana y la memoria inmunitaria.
9 Otras vías enriquecidas fueron la transcripción, la traducción, la ecdisis y los procesos metabólicos.
ValidaciónqPCRdeDEG
La qPCR confirmó los resultados de la secuenciación de ARN (RNA-seq, por sus siglas en inglés) y validó los cambios en la expresión génica relacionados con la inmunidad:
9 En las branquias se observó un aumento del factor antilipopolisacárido (ALF) a los 8 días y de la ficolina-1 (FCN1) a los 15 días, así como una disminución de la mucina 5ac (Muc5ac) a los 8 días.
9 El estómago presentó un aumento de la tiopurina S-metiltransferasa (TPMT, por sus siglas en inglés) y del inhibidor de la elastasa leucocitaria B (SERPINB1) a los 15 días.
9 Otros genes inmunitarios (profenoloxidasa [proPO], superóxido dismutasa [SOD] y lisozima [LYZ]) también se regularon al alza, en particular LYZ en las branquias (15 días).
ExpresióndiferencialdecirARN
9 Branquias: 248 circARN.
9 Estómago: 226 DEC.
9 Los ARN parentales de los DEC estaban relacionados con la memoria inmunitaria, la respuesta al estrés y la unión a toxinas.
9 La anotación de ontología genética (GO, por sus siglas en inglés) indicó que desempeñan funciones moleculares (unión hemo/ión), entrecruzamiento de péptidos y remodelación celular.
Validación de cirARN expresadosdiferencialmente (DEC)medianteqPCR
9 DEC validadas: proteína similar a la molécula de adhesión celular del síndrome de Down (DSCAM), proteína de choque térmico 70 kDa “heat shock 70 kDa protein cognate 4-like” (HSP70), aminopeptidasa N (APN) y extensina (ETX).
9 Los patrones de expresión génica de los ARN parentales coincidían en gran medida con los circARN, lo que confirma la modulación tras la suplementación con FD-LAB.
Inmunidadentrenaday resistenciaapatógenos
Pruebas de desafío con V. parahaemolyticus (VPAHPND) y WSSV:
9 La alimentación con FD-LAB durante 15 días aumentó significativamente la supervivencia de los camarones frente a ambos patógenos.



9 La alimentación durante 8 días mejoró la supervivencia frente a VPAHPND, pero no frente a WSSV.
9 La alimentación posterior a FD-LAB (7-14 días) mejoró la supervivencia, lo que indica la existencia de posibles mecanismos de inmunidad entrenados (Figura 2).
Discusión
FD-LABmejoralainmunidady lamemoriainmunológicadel camarón
La suplementación dietética con L. plantarum (FD-LAB) indujo cambios transcriptómicos significativos en P. vannamei, particularmente en genes relacionados con la inmunidad y la memoria inmunológica. El cultivo completo de FD-LAB contiene compuestos bioactivos que aumentan su potencial probiótico. El análisis del transcriptoma reveló la expresión diferencial de Muc5ac, un componente clave de la barrera mucosa, se reguló a la baja en las branquias, lo que podría influir en la resistencia a patógenos.
Las proteínas inmunitarias reguladoras, como SERPINB1, se regulan al alza, lo que sugiere su papel en la modulación inmunitaria y la inhibición bacteriana. El gen antibacteriano, factor anti-lipopolysaccharide (ALF, por sus siglas en inglés) también se reguló al alza, tanto en las
branquias como en el estómago, contribuyendo a la resistencia bacteriana y viral.
Los genes relacionados con la memoria inmunitaria, como la tiopurina metiltransferasa (TPMT) y la histona H1-delta (HisH1), se expresaron de forma diferencial. La TPMT influye en la metilación del ADN, un mecanismo clave en la inmunidad entrenada, mientras que la HisH1 regula la expresión de genes inmunitarios y tiene propiedades antimicrobianas. La regulación al alza de la ficolina-1 (FCN1), implicada en el reconocimiento de patógenos y la fagocitosis, sugiere una mejora de la respuesta inmunitaria. Estos cambios en los receptores de reconocimiento de patógenos (PRR, por sus siglas en inglés) indican un cebado inmunológico, una característica distintiva de la inmunidad entrenada.
Los cirARN actúan como reguladoresinmunitarios
La suplementación con FD-LAB también moduló la expresión de los circARN, que desempeñan un papel crucial en la regulación inmunitaria. Algunos ejemplos notables son DSCAM, HSP70, EXT y APN. La DSCAM está relacionada con la memoria inmunitaria y la inmunidad específica frente a patógenos, mientras que la HSP70 funciona

Las pruebas de desafío demuestran que la suplementación con FD-LAB mejoró la resistencia de los camarones al Vibrioparahaemolyticus (VPAHPND) y al virus del síndrome de la mancha blanca. (WSSV).

como un patrón molecular asociado a daños (DAMP, por sus siglas en inglés) que activa las respuestas inmunitarias innatas. EXT y APN se expresaron de forma diferencial, contribuyendo posiblemente a las respuestas antimicrobianas y a la resistencia a la AHPND.
Los circARN dirigidos a genes de proteínas de la cutícula estaban regulados a la baja, lo que puede haber ayudado a inhibir la infección por WSSV, mientras que los relacionados con genes Rab estaban regulados al alza, en consonancia con informes anteriores sobre la resistencia al WSSV en camarones. Estos resultados sugieren que los circARN influyen en la regulación de genes relacionados con la inmunidad y contribuyen a la inmunidad entrenada.
Inmunidadentrenaday resistenciaapatógenos
Las pruebas de desafío demuestran que la suplementación con FD-LAB mejoró la resistencia de los
camarones al V. parahaemolyticus (VPAHPND) y al WSSV. Un periodo de alimentación de 15 días aumentó significativamente la supervivencia frente a ambos patógenos, mientras que un periodo de 8 días proporcionó protección frente al V. parahaemolyticus, pero no frente al WSSV.
Siete días después de la ingesta de FD-LAB, los camarones seguían mostrando mayores tasas de supervivencia frente a ambos patógenos, lo que sugiere que han desarrollado inmunidad entrenada. Sin embargo, después de 14 días, seguía habiendo protección contra el WSSV, pero no contra el VPAHPND, lo que indica la existencia de una memoria inmunitaria específica para cada estímulo.
Conclusión
La suplementación con FD-LAB mejora la inmunidad del camarón a través de la expresión diferencial de genes relacionados con la inmunidad y circARN. El cebado inmuno-
lógico inducido mejora el reconocimiento de patógenos, las respuestas antimicrobianas y la regulación epigenética, lo que convierte a FD-LAB en un prometedor aditivo funcional de los alimentos para la prevención de enfermedades en la acuicultura del camarón.
Esta es una versión resumida desarrollada por el equipo editorial de Panorama Acuícola Magazine del artículo “TRANSCRIPTOME ANALYSES OF MRNA AND CIRCULAR RNA REVEAL DIETARY SUPPLEMENTATION WITH FREEZE-DRIED LACTIPLANTIBACILLUS PLANTARUM PRIMES IMMUNE MEMORY OF WHITELEG SHRIMP(PENAEUSVANNAMEI)AGAINST PATHOGENS”escritoporDOMINGO GUZMAN,J.–TokyoUniversityof MarineScienceandTechnologyand IndustrialTechnologyDevelopment Institute,NOZAKI,R.;KOIWAI,K.,KONDO, H.andHIRONOI.–TokyoUniversityof MarineScienceandTechnology,AOKI, M;KUWAHARA,H.and MIKATA,K. –Sumitomo Chemicals Co.,Ltd. La versión original, incluyendo tablas y figuras, fue publicada en DICIEMBRE de 2024 en FISH AND SHELLFISH IMMUNOLOGY. Se puede acceder a la versión completa a través de https://doi.org/10.1016/j.fsi.2024.110091

El sistema de estanques en “raceways” (IPRS, por sus siglas en inglés) es un sistema donde se concentran los peces, y permite una adecuada alimentación y una cosecha más ágil. Por tanto, más ciclos de producción, mejores tratamientos en caso de necesitar y, en general, un mejor manejo del cultivo… Y hasta aquí, todo parecería sencillo, un sistema de cultivo intensivo más. Sin embargo, el modelo ofrece ventajas adicionales.
Por: Marco A. Ross*
Del día 3 al 5 de diciembre de 2024 en la ciudad de La Paz, Baja California Sur, nos reunimos a invitación de la Sociedad Americana de la Soya (USSEC, por sus siglas en inglés), quien promovió la Misión Técnica de Peces Marinos en México. Al llamado de Jairo Amezquita, gerente regional del programa de




En una superficie de 1 hectárea, se utiliza el 2%, para los canales de producción, sí es correcto, el “dos por ciento”, y lo demás se utiliza como zona de amortiguamiento.
Acuacultura-Américas USSEC, acudimos con la finalidad de conocer algunos y actualizarnos otros sobre varios temas, el principal, el sistema de estanques en “raceways” (IPRS, por sus siglas en inglés). Merece mención especial su manejo de la agenda, con una puntualidad inglesa llevó a cabo el seguimiento desde su inicio hasta el final. Respetando siempre el programa planteado. El IPRS es un sistema donde se concentran los peces, y permite una adecuada alimentación y una cosecha más ágil. Por tanto, más ciclos de producción, mejores tratamientos en caso de necesitar y, en general, un mejor manejo del cultivo… Y hasta aquí, todo parecería sencillo, un sistema de cultivo intensivo más. Sin embargo, el modelo ofrece ventajas adicionales.
En una superficie de 1 hectárea, se utiliza el 2%, para los canales de producción, sí es correcto, el “dos por ciento”, y lo demás se utiliza


como zona de amortiguamiento. Este es quizá el verdadero activo del sistema, su bajo impacto ambiental.
La producción se obtiene de muchas maneras, pero esta optimiza el uso de espacio, agua y armoniza con el ambiente. Destaca también la estrategia de promoción por parte
de la Asociación de la soya, con visión de cadena de valor.
Si pensaste que en la Misión de Peces Marinos, la primera ponente sería agricultora… ¡Acertaste! Después de la bienvenida, fue la Sra. Cindy Pulskamp, productora de soya de Dakota del Norte, quien con
su brillo y calidez comentó que ahí ha estado la familia ya por más de 110 años. Sin duda, una verdadera productora de soya. Mostró cómo se lleva a cabo el cultivo, que por cierto también presenta un alto nivel tecnológico. Ella y su esposo trabajan directamente en el campo, integran

Hoy el medio ambiente y los consumidores así lo requieren; no se trata de producción o conservación, sino de producción y aprovechamiento sustentable; no uno u otro, se trata de producir en armonía y llegar al mercado con la mejor calidad y precio.



drones y nutrientes específicos al cultivo a fin de optimizarlo y así proveer de un insumo de la más alta calidad a los mercados, la Soya de Estados Unidos.
Es relevante, y mucho, como la Asociación Americana de la Soya fortalece los enlaces entre agricultores y acuicultores, con la finalidad de hacer llegar a ambos de forma más competitiva a los mercados.
Adicional a ello, consultores expertos en acuicultura e ingeniería en cultivos, como: Jesse Chapppell, Zhou Enhua, Tiger Ge, Stephen Gunther y Hsiang Ping Lan, mostraron el avance del IPRS, principalmente en Asia y América Latina, donde hoy por hoy se posiciona más cada día.
La misión permitió además visitar las instalaciones de SANTOMAR, empresa líder en México en la producción de totoaba (Totoaba macdonaldi), pargo rojo (Lutjanus peru) y ostión (Crassostrea gigas), y de la empresa OMEGA BLUE, productores de jurel (Seriola rivoliana) Así mismo se visitó CIBNOR, centro de investigaciones donde se pudo observar los reproductores de robalo (Centropomus spp) y su manejo.
¡Vaya semana! En un periodo muy breve, la USSEC, promovió un intercambio de ideas y experiencia entre empresas, proveedores, centro de investigación y empresarios interesados en los nuevos modelos de producción.
Sin decirlo abiertamente, estábamos ante un creativo modelo de fortalecimiento de cadenas de valor, donde desde el cultivo de soya en EE. UU., se daba impulso al cultivo de peces marinos y dulceacuícolas. Seguro pronto estaremos viendo más estos sistemas.
Hoy el medio ambiente y los consumidores así lo requieren; no se trata de producción o conservación, sino de producción y aprovechamiento sustentable; no uno u otro, se trata de producir en armonía y llegar al mercado con la mejor calidad y precio. ¡Qué mejor forma que integrando las cadenas productivas!.
Producir 3.3 kg/m3 utilizando el 2% de la superficie, y el área restante como amortiguamiento, ¿por qué usar más? Bien vale la prueba, ¿no?
Estaremos pendientes de los avances.
* Marco A. Ross Oceanólogo



Los Copépodos Frozen Ocean® son una fuente natural, rica en nutrientes, ideal para alimentar organismos acuáticos en sus primeras etapas de desarrollo. Estos pequeños crustáceos forman parte fundamental del zooplancton y tienen un papel esencial en la cadena trófica acuática. Su disponibilidad durante todo el año simplifica su uso en la acuicultura.
Por: Redacción de PAM*
La biodiversidad única del mundo marino, lo distingue como una fuente indispensable de recursos que alimentan y nutren a muchas especies, tanto en los ecosistemas naturales como en la acuicultura. Uno de estos importantes organismos marinos son los copépodos, que nutren a las especies acuáticas en sus primeras etapas de desarro-
llo. Los copépodos son pequeños crustáceos que forman parte primordial del zooplancton. Estos organismos marinos representan una porción vital de la cadena trófica en ambientes acuáticos, debido a que son aprovechados como fuente primaria de alimento para una amplia diversidad de especies marinas, que incluyen peces, moluscos y crustáceos. En este con-
texto, el concepto innovador de los Copépodos Frozen Ocean® es de utilidad en la investigación científica para la mejora de la nutrición de especies marinas y en la acuicultura, debido a su alto valor nutricional y sus propiedades biológicas únicas. En cuanto a sus características físicas, los copépodos son artrópodos diminutos; sin embargo, tienen un rol central en los ecosistemas
acuáticos. Forman parte del grupo de los crustáceos y se distinguen por unas antenas muy alargadas que le permiten nadar con gran agilidad. Son abundantes en la vida acuática y su distribución geográfica abarca una gran parte de los océanos alrededor del mundo, con mayor prevalencia en aguas frías y ricas en nutrientes, tales como las del Círculo Polar Ártico. En línea con la importancia y características de estos pequeños crustáceos, surge la iniciativa de los copépodos congelados 100% naturales, de Frozen Ocean®, esterilizados y certificados libres de virus, buscando preservar estos organismos de manera que mantengan intactas sus propiedades físicas, biológicas y nutricionales, y brinden una fuente de alimento de alta calidad para especies marinas de fase larval.
Perfil nutricional y digestibilidad de los
Copépodos Frozen Ocean®
Uno de los beneficios principales de los copépodos como fuente de alimentos para organismos acuáticos, es su excelente perfil nutricional. Por tanto, los Copépodos Frozen Ocean® son ricos en ácidos grasos esenciales y proteínas de alta calidad. Esta mezcla de nutrientes, los califica como una excelente opción para promover el desarrollo y el crecimiento de larvas juveniles de diversas especies. Además, el alto contenido energético que suministra es clave durante las etapas tempranas de vida de las especies acuáticas, cuando requieren un aporte nutricional superior para un desarrollo, crecimiento y supervivencia adecuados.
Beneficios de la astaxantina en los
Copépodos Frozen Ocean®
Otro aspecto que es importante resaltar de los Copépodos Frozen Ocean® es su capacidad para contener astaxantina, un pigmento carotenoide de color rojo-anaranjado que actúa como un potente antioxidante. La astaxantina es vital para la salud de los organismos acuáticos, ya que ayuda a fortalecer su sistema inmunológico, promueve la salud celular y protege contra los efectos dañinos de los radicales libres. Este compuesto también mejora la calidad de los productos acuáticos destinados al consumo humano, otorgando

El concepto innovador de los Copépodos Frozen Ocean® es de utilidad en la investigación científica para la mejora de la nutrición de especies marinas y en la acuicultura, debido a su alto valor nutricional y sus propiedades biológicas únicas.
color y sabor. Esta propiedad hace que los Copépodos Frozen Ocean® sean una opción aún más valiosa en la acuicultura, ya que no solo proporcionan nutrientes esenciales, sino que también mejoran el aspecto final de los productos acuícolas.
Los Copépodos Frozen Ocean® ofrecen una opción segura
La esterilización de los Copépodos Frozen Ocean® es un proceso muy importante, ya que garantiza la seguridad de este recurso biológico. El proceso de esterilización por irradiación gamma asegura que los copépodos estén libres de virus, patógenos y otros microorganismos peligrosos que podrían comprometer la salud de las especies acuáticas (Tabla 1). Este aspecto es clave en la industria acuícola, donde las enfer-
medades pueden propagarse rápidamente entre las especies, afectando la producción y la calidad de los cultivos. Los Copépodos Frozen Ocean®, al estar esterilizados por irradiación gamma, ofrecen una opción segura y controlada para la alimentación de las larvas y otros organismos marinos.
Características y especificaciones de los Copépodos Frozen Ocean®
Entre las características principales de los Copépodos Frozen Ocean® destacan las siguientes:
3 Es un producto seguro, esterilizado por irradiación gamma.
3 Cuenta con una alta disponibilidad de nutrientes para promover el crecimiento y la supervivencia del organismo.
Parámetro Valores
Virus (WSSV, IHHNV, YHV, TSV, IMNV, PvNV, MrNV, AHPND/EMS, NHP-B)
No Detectado
Salmonella sp (/25g) No Detectado Escherichia coli (/g) No Detectado
Vibrio spp (/g) No Detectado
Shigella (/25g) No Detectado
Listeria (/g) No Detectado
Etoxiquina No Detectado
Antibiótico No Detectado
Conteo Aeróbico Total (máx.) 0.0 x 101 cfu/g
Tabla 1. Valores de bioseguridad.
3 Es 100% natural.
3 Congelado rápido para mantener intacto su valor nutricional.
3 Constituye un sustituto probado de hasta el 100% de los quistes de Artemia, manteniendo la calidad de los organismos y los niveles de producción.
El producto está compuesto al 100% por copépodos (Cyclops sp). Se ofrecen dos rangos de tamaño: de 500 a 800 µm (aproximadamente 20,000 organismos por gramo) y de 700 a 1,300 (aproximadamente 10,000 organismos por gramo). Los valores nutricionales típicos proporcionados corresponden a un producto de origen natural (Tabla 2), y la información suministrada se basa en el mejor conocimiento disponible, entendiendo que no garantizan características específicas del producto.
Ventajas de los
Copépodos Frozen Ocean®
El uso de copépodos congelados esterilizados en el cultivo de larvas de camarón y peces ofrece una serie de ventajas significativas, las cuales se reflejan en importantes aspectos de la actividad acuícola:
Ventajas nutricionales
3 Perfil nutricional superior. Los copépodos son una fuente natural de alimento para larvas de peces y camarones, los cuales ofrecen un perfil nutricional más completo que la Artemia, incluyendo ácidos grasos esenciales como el ácido docosahexaenoico (DHA, por sus siglas en inglés) y el ácido eicosapentaenoico (EPA), que son cruciales para el desarrollo larvario.
3 Mayor digestibilidad. Su tamaño pequeño y su exoesqueleto blando los hacen más fáciles de digerir para las larvas, especialmente en etapas tempranas. Esto se traduce en un mejor crecimiento y supervivencia.
Parámetro Valores
Humedad 82%
Proteína 68%
Lípidos 16%
DHA (22:6ω3) 17 mg/g del peso seco
EPA (20:5ω3) 10 mg/g del peso seco Tabla 2. Valores nutricionales típicos (base materia seca).
Ventajas de manejo
3 Disponibilidad. Los copépodos congelados están disponibles todo el año, eliminando la dependencia de la producción de Artemia o la recolección de plancton, que puede ser variable e impredecible.
3 Facilidad de uso. Se pueden almacenar fácilmente y descongelar según sea necesario, lo que simplifica la alimentación de las larvas y reduce los requerimientos de mano de obra.
3 Dosificación precisa. Permite un mejor control sobre la cantidad de alimento que se suministra a las larvas, evitando el desperdicio y la contaminación del agua.
Ventajas sanitarias
3 Esterilización. El proceso de esterilización por irradiación gamma elimina bacterias, virus y parásitos que pueden ser perjudiciales para las larvas, mejorando la bioseguridad del cultivo.
3 Reducción de enfermedades. Al eliminar los patógenos, se reduce el riesgo de enfermedades en las larvas, lo que aumenta la supervivencia y la producción.
3 Mejor calidad del agua. Al ser un alimento limpio y de fácil digestión, los copépodos congelados contribuyen a mantener una mejor calidad del agua en los tanques de cultivo.
Ventajas económicas
3 Eficiencia. Aunque el costo inicial puede ser mayor que el de la Artemia, la mayor supervivencia y crecimiento de las larvas, junto con la reducción de enfermedades y la mejora en la calidad del agua, pueden resultar en una mayor eficiencia económica a largo plazo.
3 Reducción de costos. Al simplificar el manejo y la alimentación, se pueden reducir los costos de mano de obra y la necesidad de tratamientos para enfermedades.
En resumen, el uso de los Copépodos Frozen Ocean®, congelados y esterilizados, en el cultivo de larvas de camarón y peces ofrece una serie de ventajas que permiten mejorar la eficiencia, la rentabilidad y la sostenibilidad de la producción.
Uso de los Copépodos
Frozen Ocean®
En cuanto a las instrucciones de uso, para el reemplazo de quistes de Artemia se recomienda una proporción de 1:1 de biomasa de nauplios de Artemia por biomasa de copépodos. Si se usa como alimento complementario, se debe consultar la tabla sugerida de alimentación que acompaña al producto.
El primer paso recomendado es pesar la cantidad de producto congelado necesaria y retirar el producto de su bolsa. A continuación, descongelar el producto en un recipiente con agua limpia, preferiblemente con salinidad similar a la del tanque que se va a alimentar, evitando agitar mientras se descongela. Luego, dispersar el producto descongelado sobre la superficie del tanque y ajustar la dosis según el desempeño del organismo.
Una vez que el producto se descongele, no se debe volver a congelar. En este caso, se recomienda almacenar en el refrigerador durante un periodo de hasta 3 días.
Los Copépodos Frozen Ocean® representan una alternativa de nutrición rica y segura para la alimentación de organismos acuáticos en sus primeras etapas de desarrollo. Su perfil nutricional excepcional, junto con la presencia de astaxantina como antioxidante y el proceso de esterilización por irradiación gamma, hacen de este producto una opción ideal para la acuicultura moderna, contribuyendo al crecimiento saludable de las especies acuáticas y al mejoramiento de los procesos productivos en este sector.

Este artículo es patrocinado por MEGASUPPLY.
Esta es una versión resumida desarrollada por el equipo editorial de Panorama Acuícola Magazine del artículo “FROZEN OCEAN® COPÉPODOS CONGELADOS 100% NATURAL, ESTERILIZADO” escrito por MEGASUPPLY. La versión original, incluyendo tablas y figuras, fue publicada COPÉDPODOS FROZEN OCEAN® FICHA TÉCNICA.




























































Efectos de dietas formuladas con diferentes combinaciones de ingredientes alternativos para alimentos sobre el crecimiento, la digestibilidad aparente, las enzimas digestivas y las actividades de expresión génica del camarón blanco del Pacífico, Penaeus vannamei
A medida que la acuicultura se esfuerza por lograr la sostenibilidad, la sustitución de la harina de pescado en las dietas de los camarones sigue siendo un reto. Este estudio explora una combinación innovadora de harina de subproductos avícolas, harina de insectos, harina de maní, harina de canola, proteína unicelular y residuos de pescado. Los resultados muestran una mejora en las tasas de crecimiento, un uso eficaz de nutrientes y una expresión génica estable, lo que demuestra que las fuentes alternativas de proteínas pueden mantener la salud de los camarones. Este avance favorece una acuicultura respetuosa con el medio ambiente sin comprometer el rendimiento.
Por: Redacción de PAM*
Una dieta que combine ingredientes novedosos, accesibles y sostenibles puede satisfacer mejor las necesidades nutricionales de los
camarones y reducir la dependencia de la harina de pescado (FM, por sus siglas en inglés). Este enfoque garantiza un perfil nutricional equilibrado que fomenta la acuicultura sosteni-
ble. Ante la creciente demanda de FM, la industria ha adoptado combinaciones alternativas de ingredientes, lo que promueve soluciones de alimentación eficaces y respetuosas
Para hacer frente a la creciente demanda de harina de pescado, la industria ha adoptado combinaciones alternativas de ingredientes, lo que ha dado lugar a soluciones de alimentos eficaces y respetuosas con el medio ambiente.
con el medio ambiente. Esta estrategia no solo sustenta el crecimiento del camarón, sino que también mejora la asimilación de los nutrientes. El presente estudio evalúa el impacto de varias combinaciones de ingredientes en el rendimiento del crecimiento y la eficiencia de nutrientes del Penaeus vannamei, con el objetivo de desarrollar alternativas sostenibles que apoyen la viabilidad de la industria a largo plazo.
Material y métodos
El estudio se llevó a cabo en un tanque de cría de 32 m³ en Koovathur (Tamil Nadu, India), donde se criaron postlarvas (PL12) de P. vannamei hasta juveniles (1 g) con aireación continua. Los juveniles fueron alimentados con una dieta comercial (Royal Dragom DT311) cuatro veces al día. En un ensayo de alimentación de ocho semanas, se utilizaron tanques de 150 L (un control y cuatro tratamientos, con tres repeticiones). Se distribuyeron 35 camarones (peso inicial: ~1.05 ± 0.03 g) por tanque y se les alimentó hasta la saciedad. Se cambió el agua salada (15 ± 1 ppt) cada tres días y se controló la calidad de la misma.
Se formularon cinco dietas isonitrogenadas (36% de proteína cruda, CP) e isolipídicas (6% de grasa cruda, CF) con diferentes fuentes de proteínas. Las dietas experimentales se elaboraron de las siguientes maneras: Dieta 1 (dieta de control), la FM fue la fuente principal de proteína; Dieta 2, la FM se sustituyó por harina de subproductos avícolas (PBM, por sus siglas en inglés) y proteína unicelular (SCP) (1:1); Dieta 3, la FM se sustituyó por harina de
insectos (IM), harina de canola (RM) y proteína unicelular (SCP) (1:1:1); Dieta 4, se sustituyó la FM por residuos de pescado (FW), harina de maní (PM) y SCP (1:1:1), y Dieta 5, se sustituyó la FM por PBM, SCP, IM, RM, FW y PM (1:1:1:1:1:1). Los ingredientes se molieron finamente, se homogeneizaron, se granularon (1.6 mm) y se secaron a 45°C antes de almacenarlos a 4°C. Se añadió óxido crómico como marcador inerte para determinar la digestibilidad. Tras ocho semanas, se anestesiaron y pesaron los camarones. Se evaluó el rendimiento del crecimiento, a través de los siguientes indicadores: factor de conversión alimenticia (FCR, por sus siglas en inglés), tasa de crecimiento específico (SGR), crecimiento diario medio (ADG), tasa de eficiencia proteínica (PER) y supervivencia. La composición aproximada del cuerpo entero se analizó siguiendo los protocolos de la Asociación de Químicos Analíticos (AOAC, 2010). El contenido de aminoácidos se determinó mediante cromatografía líquida a ultrapresión (UPLC, por sus siglas en inglés), mientras que la composición de ácidos grasos se evaluó mediante cromatografía de gases. Las enzimas digestivas (lipasa, proteasa y amilasa) se cuantificaron a partir de muestras de hepatopáncreas e intestino. La expresión génica de IGF-I e IGF-II se analizó mediante reacción en cadena de polimerasa (PCR, por sus siglas en inglés) en tiempo real, empleando la β-actina como gen de referencia. Se recolectaron muestras fecales, se secaron y se analizó la digestibilidad mediante un espectrómetro de
plasma de acoplamiento inductivo. La digestibilidad se calculó a partir del contenido de óxido crómico. Esta metodología garantizó una evaluación precisa de los efectos de la dieta en el crecimiento de los camarones y en el uso de los nutrientes.
Crecimiento y uso de los alimentos
Los resultados del ensayo de crecimiento a los 60 días mostraron que los camarones alimentados con las dietas 1, 3 y 5 presentaron un peso final y ADG significativamente superiores. La SGR fue mayor en las dietas 1 (4.66 ± 0.14) y 5 (4.60 ± 0.06), sin evidenciar diferencias significativas con la dieta 3 (4.55 ± 0.07). El FCR fue significativamente inferior en las dietas 1 y 5 (1.26 ± 0.03 y 1.24 ± 0.04, respectivamente). La PER también fue mayor en los camarones alimentados con las dietas 1 y 5. No se observaron diferencias significativas (p > 0.05) en la supervivencia de los camarones en todas las dietas.
Composición aproximada del cuerpo entero
La composición de cuerpo entero (Tabla 1) indicó un contenido significativamente mayor de proteína bruta en los camarones alimentados con la dieta 5 (18.04 ± 0.27), similar al de las dietas 1 (17.84 ± 0.14) y 2 (17.64 ± 0.27). El contenido de lípidos fue significativamente inferior en los camarones alimentados con las dietas 2 y 3. No se observaron diferencias significativas en el contenido de humedad y cenizas en todas las dietas.


Coeficiente de digestibilidad aparente
La digestibilidad de la materia seca fue significativamente mayor en los camarones alimentados con las dietas 5 y 1, y se observó una tendencia similar en la digestibilidad de la proteína bruta. La digestibilidad de los lípidos brutos fue mayor en los camarones alimentados con la dieta 1 (76.26 ± 0.53).
Actividad enzimática digestiva
La actividad enzimática del hepatopáncreas mostró una actividad de la amilasa significativamente mayor en los camarones alimentados con la dieta 5, similar a la dieta 3. La actividad de la proteasa fue significativamente mayor en los camarones alimentados con la dieta 2 (76 ± 0.53). La actividad de la lipasa fue mayor en la dieta de control.
La actividad de las enzimas intestinales mostró una mayor actividad de la amilasa en los camarones alimentados con la dieta 1. No se observaron diferencias significativas en la actividad de la proteasa entre las dietas 3 y 5. Los camarones alimentados con la dieta 2 presentaron la menor actividad de lipasa.
Actividad de expresión génica
Los datos de expresión génica del crecimiento (IGF-I e IGF-II) mostraron un aumento significativo de la expresión de IGF-I (p < 0.05)
en los camarones alimentados con dietas específicas, lo que indica un mayor rendimiento en el crecimiento (Figuras 1 y 2).


La actividad de las enzimas digestivas es fundamental para la absorción de nutrientes. Las actividades de amilasa y proteasa en el hepatopáncreas, y de amilasa y lipasa en el intestino medio, eran comparables en todas las dietas, lo que garantiza una digestión y absorción eficientes de carbohidratos, proteínas y lípidos.

La sustitución de FM por fuentes proteínicas alternativas en las dietas de camarones, especialmente en el caso de P. vannamei, ha supuesto todo un reto cuando se ha intentado a niveles elevados o en sustitución total. Sin embargo, algunos estudios sugieren que la FM puede sustituirse totalmente por subproductos terrestres y proteínas vegetales sin afectar al crecimiento o la supervivencia de los camarones. En este estudio se evaluó una dieta que combinaba varios ingredientes alternativos y se observó una mejora de la SGR y del FCR, probablemente debido a su perfil equilibrado de aminoácidos. En particular, la expresión de los genes IGF-I e IGF-II en camarones alimentados con la dieta 5 (sin FM) fue similar a la de camarones alimentados con una dieta con un 20% de FM, lo que indica que no hubo efectos adversos en el crecimiento. Por lo tanto, la dieta 5, compuesta por PBM, IM, FW, RM, PM y SCP, puede sustituir eficazmente la FM

En este estudio se evaluó una dieta que combinaba varios ingredientes alternativos y se observó una mejora de la tasa de crecimiento específico (SGR, por sus siglas en inglés) y del factor de conversión alimenticia (FCR), probablemente debido a un perfil equilibrado de aminoácidos.
en las dietas para camarones, sin comprometer el crecimiento ni el uso de nutrientes.
El análisis de la composición de cuerpo entero no mostró diferencias significativas en el contenido total de cenizas, humedad o proteína bruta entre las dietas 1, 2 y 5. El contenido de lípidos brutos también fue similar en las dietas 1, 4 y 5, lo que corrobora la conclusión de que las proteínas alternativas proporcionan una nutrición adecuada. Estos resultados concuerdan con el rendimiento del crecimiento y la expresión génica relacionada con este.
La actividad de las enzimas digestivas es fundamental para la absorción de nutrientes. Las actividades de amilasa y proteasa en el hepatopáncreas, y de amilasa y lipasa en el intestino medio, fueron comparables en todas las dietas, lo que garantiza una digestión y absorción eficientes de carbohidratos, proteínas y lípidos. Esta eficiencia se correlaciona con el coeficiente de digestibilidad aparente, mayores actividades de enzimas digestivas y genes de crecimiento regulados, lo que contribuye a un mejor uso de los nutrientes.
Una alta digestibilidad es esencial para sustituir la FM. En este estudio,
la digestibilidad de la proteína bruta y de la materia seca fue similar en las dietas 1 y 5, lo que indica que las fuentes alternativas de proteína se usaron de manera eficiente. Además, la expresión de los genes IGF-I e IGF-II aumentó en las dietas 1 y 5, evidenciando una estrecha relación entre crecimiento, actividad de enzimas digestivas y mejora de la salud y la supervivencia de los camarones.
Conclusión
Los resultados de esta investigación han revelado que una combinación de ingredientes que contiene harina de subproductos avícolas (PBM) + harina de insectos (IM) + harina de canola (RM) + harina de maní (PM) + proteína unicelular (SCP) + residuos de pescado (FW) en proporción (1:1:1:1:1:1) ha dado los mejores resultados, ya que satisface las necesidades nutricionales de los camarones sin comprometer su crecimiento ni el uso de nutrientes. Además, la expresión de los genes IGF-I e IGF-II y la actividad de las enzimas digestivas confirman que esta combinación de la dieta es la mejor para apoyar el rendimiento de crecimiento y el uso de nutrientes en el cultivo de P. vannamei.

La versión informativa del artículo original está patrocinada por: North American Renderers Association (NARA)
Esta es una versión resumida desarrollada por el equipo editorial de Panorama Acuícola Magazine del artículo “EFFECTS OF DIETS FORMULATED WITH DIFFERENT COMBINATIONS OF NOVEL FEED INGREDIENTS ON GROWTH PERFORMANCE, APPARENT DIGESTIBILITY, DIGESTIVE ENZYMES AND GENE EXPRESSION ACTIVITIES OF PACIFIC WHITE SHRIMP, PENAEUS VANNAMEI)” escrito por RAJALAKSHMI, K., FELIX, N., RANJAN, A. and SATHISHKUMAR, G. Tamil Nadu Dr. J. Jayalalithaa Fisheries University; ARUMUGAM, U. Dr. MGR Fisheries College and Research Institute and ISHFAQ NAZIR, M Sher-E-Kashmir University of Agricultural Sciences and Technology. La versión original, incluyendo tablas y figuras, fue publicada en DICIEMBRE de 2024 en AQUACULTURE INTERNATIONAL. Se puede acceder a la versión completa a través de https://doi.org/10.1007/s10499-02401803-x
RESTAURANTES SUPERMERCADOS

Se procesan en porciones más pequeñas, para luego ser cocidos y separados en grasas y proteínas
Los residuos de proteínas animal y vegetal llegan a nuestra planta desde restaurantes, supermencados y otros GRASAS PURIFICADAS POR CENTRÍFUGA
PRODUCTOS LISTOS PARA SER USADOS EN LA
GRASAS PROTEÍNAS
PROTEÍNAS PORCIONADAS


Durante los cultivos, los tanques de laboratorio tienen que equilibrar la máxima densidad de larvas y las altas concentraciones de materia orgánica que deterioran la calidad de agua y los fondos provocando acumulación de amoniaco, nitritos y sulfuros. Las enzimas de Biodigester, producto orgánico natural compuesto por extracto de levadura
Saccharomyces cerevisiae, con alto contenido de nucleótidos, han demostrado que contribuyen a disminuir los valores de nitritos, amonio no ionizado y sólidos suspendidos presentes en los estanques.
Por: Ing. Richard Martin*
El nitrógeno amoniacal total (TAN, por sus siglas en inglés) está constituido por amonio ionizado (NH4) y amonio no ionizado (NH3). Al aumentar el pH (desde 7.5 a 8.5) y la temperatura (desde 25-35°C), se incrementa la forma de amonio no ionizado NH3, el cual es más tóxico para los camarones. Cuando el amonio es liberado hacia el ambiente acuático y se acumula en concentraciones grandes, puede crear problemas de estrés en los camarones. Generalmente, las consecuencias son malos crecimientos y conversiones, e incluso ocurren efectos adversos bajo exposiciones prolongadas de 1 ppm.
Determinados grupos bacterianos se emplean para la biorremediación de los estanques. Estos grupos usan la materia orgánica como fuente de nutrientes, lo cual reduce la cantidad de desecho acumulado en el estan-
que (Miramontes–Higuera, 2004). Además, las bacterias nitrificantes y desnitrificantes específicas convertirán el NH3 y el NO2– en gas nitrógeno, reduciendo así el nivel de estos compuestos tóxicos (Hargreaves, 1998). Algunas bacterias beneficiosas también pueden degradar el H2S tóxico, mejorando la calidad del agua y el olor.
En el proceso de biorremediación, las enzimas de estos microorganismos desempeñan el papel de catalizadores, los cuales aceleran las reacciones bioquímicas en el suelo y el agua del estanque (Csavas,1994). Cuando se le añade al agua de cultivo, o se disemina por todo el suelo del estanque, las enzimas son capaces de degradar los principales constituyentes orgánicos que normalmente se encuentran en los estanques de peces y camarones (Ritvo et al., 1998). Cada enzima tiene su propio modo de acción y
es muy específica en la reacción química que cataliza.
Algunos microorganismos son capaces de excretar enzimas al medio. Estas enzimas extracelulares, como celulasa, proteasa y amilasa, se producen durante la fermentación aeróbica de la materia orgánica, por ejemplo, en algunas especies de Bacillus (Catedral et al., 1977). No existe ninguna enzima específica que funcione bien en todos los casos, por lo que se aconseja una mezcla de enzimas para actuar de manera eficaz en la biorremediación. Este artículo resume los resultados más relevantes de un estudio en el cual se determinó la efectividad de Biodigester en el proceso de cultivo de larvas de camarón, en comparación con otros dos biorremediadores, a partir de la evaluación de la cantidad de amonio (mg/L), sólidos disueltos totales (g/L) y potencial redox (mV).

Materiales y Métodos
La prueba se desarrolló en tres tanques de 40 toneladas durante 15 días, empleando un método rápido de medida de campo.
Descripcióndelazonade muestreo
El laboratorio de larvas donde se realizó la investigación cuenta con un sistema de abastecimiento y recirculación de agua del mar. Este se encuentra ubicado en la zona de Mar Bravo, en la provincia de Santa Elena, a 24 kilómetros de Salinas, Ecuador.
Metodologíademuestreo
La prueba se realizó durante 15 días para la medición de amonio no ionizado NH3, desde el inicio de la corrida hasta su cosecha. Se analizaron tres tanques identificados como TQ1, TQ2 y TQ3. Todos los tanques fueron sembrados el mismo día e iniciaron con 40 toneladas de agua, los cuales se mantuvieron con niveles de recambios normales diariamente, con una densidad de siembra inicial promedio de 250 nauplios por litro. En el tanque TQ1 se añadió Biodigester, en el tanque TQ2 el Producto A y en el tanque TQ3 el Producto B, distribuidos en dos aplicaciones al día a las 10:00 a.m. y 4:00 p.m., según la cantidad de toneladas de agua en iguales cantidades y a la misma hora. En la Tabla 1 se muestran dosificaciones recomendadas para la aplicación de los diferentes productos en el laboratorio.

Los parámetros fisicoquímicos fueron analizados a la misma hora durante 12 días. Además, el área de microbiología realizó el conteo de vibrios en los tres tanques en toda la corrida.
Análisis de datos
Se analizó amonio no ionizado por método de kit de cambio de color, basándose en una tabla referencial. Los valores fisicoquímicos de potencial redox (ORP, por sus siglas en inglés), sólidos disueltos totales (TDS), pH y temperatura, se analizaron con multiparámetro APERA PC 60 y APERA ORP.
Resultados
Siguiendo el protocolo de aplicación de los tres productos, las cantidades de amonio detectadas fueron menores en el tanque del Biodigester (< 0.25 mg/L), mientras que, en los tanques tratados con los otros dos productos, el rango se elevó hasta < 1 mg/L (Tabla 2 y Figura 1).

En cuanto a los valores de ORP, estos fueron de 135-210 mV en el tanque tratado con Biodigester, en comparación con los 136-170 mV y 129-166 mV medidos en los tanques tratados con el Producto A y el Producto B respectivamente (Tabla 3 y Figura 2).
La medición de los sólidos disueltos totales (TDS) en los tanques arrojó valores de 20-22 g/L para TQ1 con Biodigester, 20-32 g/L para TQ2 y 21-30 g/L para TQ3 (Tabla 4 y Figura 3). La alcalinidad se mantuvo para todos los tratamientos en 120 mg/L, el promedio de pH fue de 7.5 (Tabla 5) y la temperatura fluctuó entre 29.6 y 31.2°C (Tabla 6).








Biodigester produce una alta tasa de mineralización de la materia orgánica, tanto en estanques de tierra como en estanques de larvicultura, lo cual reduce la necesidad de recambios de agua, disminuyendo el riesgo de contaminación bacteriana.


Adicionalmente, en el tanque tratado con Biodigester se pudo observar una larva más robusta, en especial en el paso al estadio de mysis (Figura 4), y una menor proliferación de mucílagos (Figura 5).
Conclusiones
Se determinó que los niveles de amonio no ionizado en el TQ1 con Biodigester fueron menores en comparación con los de TQ2 y TQ3 con Producto A y Producto B respectivamente, lo cual indica que las enzimas de Biodigester degradan de forma específica los principales constituyentes orgánicos, como proteínas insolubles, almidón, celulosa, residuos vegetales y lípidos. La acumulación y la degradación de los residuos orgánicos en el tanque se traducirá en un aumento del consumo de oxígeno (O2) y la producción de compuestos de desecho como el amoníaco (NH3), nitritos (NO2–) y sulfuro de hidrógeno (H2S). Los altos niveles de amonio > 1 mg/L provocan una
disminución en el consumo de alimento y, por lo tanto, retardo en el crecimiento.
En cuanto a los valores de potencial redox (ORP), en el TQ1 con Biodigester fueron superiores conforme se avanzaba en los días de cultivo, demostrando su acción como compuesto esencial para mantener niveles óptimos.
El valor de sólidos disueltos totales (TDS) en el tanque TQ1 con Biodigester no varía significativamente durante todo el ciclo larvario de producción, notándose un mejor desempeño. Además, es importante mencionar que la dosificación en el TQ1 con Biodigester fue menor que las dosis de los otros dos productos involucrados en el estudio, lo cual se traduce en una clara ventaja costo/dosis de Biodigester ante los desafíos que representa una alta densidad de biomasa, sana y productiva.


Este artículo es patrocinado por: Nepropac de México, S.A. de C.V.
* Ing. Richard Martin Jefe de Investigación y Desarrollo Nepropac, S.A.
Las referencias y fuentes consultadas por el autor en la elaboración de este artículo están disponibles bajo petición previa a nuestra redacción.
Del 03 al 05 de septiembre de 2025, Lima será el punto de encuentro para quienes buscan innovar, fortalecer su presencia en el mercado y crear conexiones estratégicas.
Por: Comité Organizador de la “Feria Internacional Expo Pesca & Acuiperú –Seafood Lima 2025”
Durante los tres días de la feria, se exhibirán equipos, tecnologías y servicios de vanguardia diseñados para impulsar la eficiencia y la sostenibilidad en la pesca, la acuicultura y el seafood Este evento es reconocido como el más importante de la industria en la región, reuniendo a los más importantes expositores, empresarios, y profesionales del sector de todo el mundo.
¿Por qué participar en Expo Pesca & Acuiperu-Seafood Lima 2025?
1. Exhibición de Equipos y Servicios: los exhibidores presentarán lo último en tecnología de Equipos, Servicios y Suministros para Pesca, Acuicultura y Seafood
2. Visitantes de Calidad: esperamos la visita de 9,500 compradores internacionales de primer nivel del Perú y del extranjero durante los tres días del evento.
3. Congreso Técnico: durante la feria, se llevará a cabo un congreso técnico que reunirá a expertos nacionales e internacionales para abordar los principales desafíos y avances del sector.


4. Oportunidad de Demostrar el Valor de sus Productos: nada supera la experiencia en vivo. Su empresa podrá realizar demostraciones, responder preguntas al instante y destacar lo que hace único a su negocio frente a clientes potenciales.
Exhibir su marca en el evento, es una oportunidad única de mostrar sus productos y servicios a una audiencia especializada, establecer contactos clave y expandir su red de negocios.
Este artículo es patrocinado por: FERIA INTERNACIONAL EXPO PESCA & ACUIPERÚ – SEAFOOD LIMA 2025
Información de Contacto:
Para más información sobre cómo participar en el evento, favor de contactarnos a los siguientes correos o Whatsapp: Correos: bsanchez@thaiscorp.com –gdelatorre@thaiscorp.com Whatsapp: +51 987-421-834 / +51 982508-607

Al igual que los salmones regresan a su lugar de origen nadando contra la corriente, también es necesario retornar a lo básico, a los principios fundamentales que rigen los fenómenos naturales y, a partir de esta comprensión, pasar a la búsqueda de soluciones prácticas a desafíos que aquejan a la sociedad y más concretamente a las empresas que intentan resolverlos para ganar un espacio de mercado.
Por: David Ulloa Walker*
La ciencia básica y la ciencia aplicada son complementarias, pero la primera es la base para pasar a la segunda. En ocasiones, la urgencia de resultados y la ansiedad por el éxito comercial, hacen que se salten etapas y se pierda el foco de lo básico, de los fundamentos que subyacen a los fenómenos o procesos investigados, es cuando la paciencia y la perseverancia son aliados necesarios. La innovación, como resultado exitoso de ciencia aplicada, es lo que permite a las empresas generar valor para mantenerse en el tiempo en un entorno cambiante; sin embargo, se debe ser fiel y consecuente con lo que define estos procesos. La tentación de las empresas de etiquetarse como innovadoras es muy grande, ya que es un atributo valorado por el mercado, y en un mundo digitalizado, la visibilidad y aprobación son imanes para vestirse de aquello que está de moda. Lo mismo sucede con otros conceptos o cualidades atractivas para la sociedad que son tendencia, tales como: eficiencia energética, economía circular, sostenibilidad, bienestar animal, incluyendo algunas más clásicas e igual de vigentes como huella de carbono, revolución azul, tecnologías verdes o ambientalmen-

te amigables, energías renovables, carbono neutral. Todos estos conceptos tienen en común el cuidado del medio ambiente y el respeto por la naturaleza, y son frecuentemente citados en el mundo empresarial.
A fines del siglo pasado, Peter Drucker anticipó el rol fundamental de la acuicultura, siendo un visionario para su época. En su extensa obra sobre el liderazgo y la gestión de negocios, escribió respecto de la innovación, que está basada en la disciplina y trabajo metódico, más que en súbita inspiración.
Dentro de la acuicultura mundial, la industria del salmón es protagonista y está dedicada a proveer de proteína de calidad y saludable para el consumo de la población, por lo que está sometida a variadas exigencias propias del mercado de los alimentos, como de los grupos de interés (stakeholders) que incluyen al gobierno, accionistas, proveedores, clientes, comunidades locales, organismos no gubernamentales, colaboradores, entre otros. En este contexto, es clave entender que la sostenibilidad es ambiental, social y económica, por lo que solo se puede ser responsable con el medio ambiente y el entorno, cuando las empresas son viables económicamente.
Por lo tanto, en un mundo donde la acuicultura es una realidad y, en particular, la industria del salmón es una de las más destacadas, Chile forma parte de este liderazgo, como segundo productor mundial, siendo para la economía local, el principal exportador de alimento, representando el 7% de las exportaciones totales y contribuyendo con el 2.1% del PIB nacional (Banco Central de Chile)
Este posicionamiento conlleva una gran responsabilidad, por eso la innovación basada en ciencia es la clave para una mejor industria.
En mi rol laboral como gerente de una empresa proveedora de tecnología (Imenco Aqua), centraré el análisis en este segmento. Las empresas de tecnología buscan constantemente diferenciarse, agregar valor a sus productos y servicios, para ser preferidos por los clientes, esto es una condición para mantenerse vigente en un mundo altamente competitivo. La innovación puede ser a nivel de productos, de procesos o bien modelos de negocios, ya sea que se genere de manera

La innovación como resultado exitoso de ciencia aplicada es lo que permite a las empresas generar valor para mantenerse en el tiempo en un entorno cambiante; sin embargo, se debe ser fiel y consecuente con lo que define estos procesos.
disruptiva o incremental. La investigación sobre el estado del arte y como llegar a patentar los nuevos desarrollos es una práctica cada vez más necesaria y recomendable.
En mi afán permanente de investigar, estudiar y analizar el entorno, veo con preocupación que algunas empresas para mantenerse visibles caen en la tentación de usar simplemente conceptos como la innovación, solo como etiquetas. Recientemente, en una charla en la que participé en calidad de audiencia, capturó mi atención que esto es algo más común de lo que uno podría suponer y es transversal a otras industrias. De una manera bastante más dura y categórica, se ha escrito sobre este tema, con un potente y crítico mensaje como “La innovación puede ser puro teatro”, artículo de Steve Blank, algo sobre lo que debemos reflexionar, ya que el marketing puede ser seductor, pero al mismo tiempo se debe mantener la integridad, la innovación no es algo superficial.
Las empresas tecnológicas deben saber lidiar con el desafío de entregar soluciones al mercado y hacer innovación. Lo primero, a cargo del área comercial: marketing que se mide en función de las ventas, y todo el esfuerzo está puesto en el presente, es lo que se vende hoy. En cambio, la innovación, está con
la mirada en el futuro, en lo que se venderá en el mañana, requiere de otros tiempos, de un liderazgo o gobernanza propia, para hacer innovación real se requiere una estrategia, recursos, personal idóneo, es una tarea de largo aliento, con hallazgos, aciertos y errores, esto último como de manera muy acertada Thomas Edisson no llamaba fracasos, sino que había descubierto 999 formas de cómo no hacer una bombilla. También hay casos emblemáticos donde el resultado de una innovación proviene desde otro sector industrial, por ejemplo, la cremallera fue inventada para cerrar grandes bultos y esto luego se traspasó a la industria del vestido, y muchos otros donde se consiguen simplemente por “accidente”, como en el campo de la medicina, fue el origen del viagra.
Regresando al concepto del título acerca de innovar contra la corriente, es una analogía para reforzar la idea “nadar” contra la tendencia actual. Si bien las fuerzas del marketing empujan para ser percibidos como innovadores, esto solo será meritorio y real, cuando sea consecuencia de un trabajo sistemático, basado en conocimiento científico, pruebas y validaciones que den respaldo técnico a la oferta de valor de los productos y servicios que se ofrecen en el mercado.

Las empresas de tecnología buscan constantemente diferenciarse, agregar valor a sus productos y servicios, para ser preferidos por los clientes, esto es una condición para mantenerse vigente en un mundo altamente competitivo.
Una forma de hacer innovación es aprender e imitar a la naturaleza (Biomimicry), para intentar resolver desafíos tecnológicos. Un claro ejemplo de esto es el mecanismo de contracorriente, que está presente en la respiración de los salmones, durante la captación de oxígeno disuelto en el agua a nivel de las lamelas secundarias, donde la sangre circula en un sentido, y el agua en sentido opuesto, siendo un mecanismo de transferencia altamente eficiente, que ha sido imitado y se aplica en diferentes dispositivos, por mencionar uno, el intercambiador de calor.
He citado este ejemplo, no por casualidad, ya que, en un sistema de cultivo intensivo, el oxígeno disuelto es una variable crítica y disponer de dispositivos (difusores)
que transfieran de manera eficiente este gas es algo que impacta positivamente en el crecimiento y bienestar de los peces. En este caso particular, respecto de los difusores de oxígeno, rigen los mismos principios de innovación antes mencionados. En Imenco Aqua hemos trabajado en ensayos sistemáticos, metódicos, estandarizados y con base científica, para validar nuestras soluciones. Tampoco tengo dudas que la mayoría de los actuales desarrollos presentes en el mercado han transitado también desde una fase inicial de innovación, hasta convertirse en productos comerciales. Sin embargo, en lo que he sido crítico, es cuando por fines comerciales, se transgreden aplicaciones, atributos, propiedades, incluso alcances que van más allá de lo estrictamen-
te para lo cual fueron diseñados dichos productos. Un ejemplo concreto, son algunas de las publicaciones o campañas de marketing en torno a las propiedades de las nanoburbujas, que van más allá de lo estrictamente técnico, incluso omitiendo contextos relevantes al momento de compararse con otras tecnologías. En ciencia, los resultados mágicos, como la metáfora de aquellos productos que pretenden ser “bala de plata”, no forman parte del rigor científico.
En resumen, la invitación es volver a la esencia, a la ciencia que respalde los avances tecnológicos, si bien es un proceso lento y de largo plazo, siempre da sus frutos, y lo más importante es que esta forma de trabajar genera confianza tanto hacia “adentro”, hacia todos los que participan de una empresa y son testigos de estos esfuerzos, como hacia “afuera”, a los clientes que son los usuarios. El trabajo en un laboratorio, en un banco de pruebas o cualquier unidad de investigación, exige paradojalmente no pensar en el marketing, (si bien los casos exitosos están destinados al mercado), solo exige ceñirse a los resultados y hallazgos. Finalmente, hay que hacer lo correcto porque es lo correcto. Tal como Simon Sinek lo postula en su libro “El Juego Infinito”, las empresas deben tener un propósito, una causa justa que va más allá de los resultados, donde la excelencia permite a todos los jugadores (empresas) mantenerse vigentes, la trascendencia va más allá de las ganancias, es generar beneficios para todos. Por eso, es bueno nadar contra la corriente, no es ir contra los demás, sino tan simplemente volver al origen, a lo que nos motiva e impulsa a alcanzar nuestros fines.
* David Ulloa Walker. Doctor en Acuicultura, Pontificia Universidad Católica de Valparaíso. Gerente General Imenco Aqua Chile
Fotografía: Imenco Aqua


Por: Antonio Garza de Yta, Ph.D.*

Cuando uno va a Singapur siempre se pregunta cuál será la novedad. Con ese ánimo de ser sorprendido, me tocó participar en dos eventos paralelos hace un par de semanas la “Singapore International Agri-Food Week (SIAW)” y el “Asia-Pacific Agri-Food Innovation Summit”, organizados en el espectacular centro de convenciones del Marina Bay Sands.
La experiencia, en lo particular, no fue menos de lo esperado.
Para mí, Singapur siempre ha sido un ejemplo de lo que se puede lograr con ganas de hacer las cosas, disciplina y trabajo arduo. Es increíble ver como un país que tan solo en 1965 se declaró una república independiente, y el cual vivía condiciones completamente distintas a las actuales, es hoy uno de los lugares más prósperos, civilizados y seguros del mundo. Es claro que la visión del país, ayer y hoy, tienen todo que ver. Un Estado que invirtió en su gente, tanto en educación como en salud pública, y que combatió el
problema más grande de la humanidad, que es la corrupción, ve como el gran esfuerzo realizado ha rendido frutos y sus ciudadanos cuentan hoy con el pasaporte más poderoso del mundo y un futuro próspero. Cuando uno va a Singapur siempre se pregunta cuál será la novedad. Con ese ánimo de ser sorprendido, me tocó participar en dos eventos paralelos hace un par de semanas la “Singapore International Agri-Food Week (SIAW)” y el “Asia-Pacific AgriFood Innovation Summit”, organizados en el espectacular centro de convenciones del Marina Bay Sands.
La experiencia, en lo particular, no fue menos de lo esperado. Por una parte, había por lo menos tres empresas dedicadas no solamente a la producción de harina de la mosca soldado-negra, sino ya produciendo aceite, el cual como sabemos es el cuello de botella más grande que tiene la producción de alimentos acuícolas para poder satisfacer la demanda que tendremos en un plazo cada vez más corto. Traté de ver algunas publicaciones de los resultados de estos aceites en el crecimiento de especies acuícolas, pero nadie me pudo indicar alguna


publicación; sin embargo, no me imagino que esto tarde mucho. Me tocó platicar con varios fabricantes de productos derivados de algas marinas, los cuales no se dedican per se al negocio de la sustitución de la harina de pescado en las especies acuícolas, sino más bien a la inclusión de sus productos para el mercado de mascotas, pero sin duda las algas marinas tienen más aceptación y mayor mercado. El gran problema que hoy tenemos es que el contenido proteico es únicamente del 6%, y eso obviamente hace que la inclusión a gran escala de estas harinas aún no sea algo práctico ni económicamente viable. Pero déjenme enfatizar en el aún, porque para cualquier persona que entiende la escasez global de los recursos y el potencial de las algas marinas resulta obvio que estas, sin duda, son el
digerible, pero bueno, Roma no se construyó en un día, y más vale que cuanto antes nos pongamos a trabajar si queremos contribuir con una solución real para los problemas de las futuras generaciones. Por último, lo que más me llamó la atención fue la gran cantidad de oferta de proteína animal producida en laboratorio. Hace apenas unos años esta era una idea muy atractiva, hoy ya son varias las empresas que están ofreciendo este producto, y no solo pescados y mariscos sino también animales terrestres. Es obvio que, cada vez, este mercado empezará a ser de mayor tamaño y valor, y que una porción de mercado será satisfecha por proteína de esta fuente. Existen para ellos los mismos retos que tenemos todos, reducir y optimizar el costo de producción por gramos de carne o pro-
ojos abiertos, y más aún nuestras mentes. La única constante de la humanidad es el cambio y el futuro muy probablemente sea distinto a lo que hoy imaginamos, pero, cualquiera que este sea, la acuicultura ocupará un lugar preponderante. La mayor riqueza de nuestra industria es la diversidad, y produzcamos lo que produzcamos en donde quiera que sea que lo hagamos, nuestro negocio, y el futuro de la humanidad, depende que seamos cada vez mejores en ello.
* Antonio Garza de Yta es COO de Blue Aqua International-Gulf, vicepresidente del Centro Internacional de Estudios Estratégicos para la Acuacultura (CIDEEA), presidente de Acuacultura sin Fronteras (AwF), expresidente de la Sociedad Mundial de Acuacultura (WAS), exsecretario de Pesca y Acuacultura de Tamaulipas (México) y creador de la Certificación para Profesionales en Acuacultura (CAP) junto con la Universidad de Auburn.


Organizadores:
Organizadores Locales:


Premier sponsors






Por: Stephen G. Newman*

Los antibióticos son sustancias químicas que interfieren en los procesos metabólicos de bacterias y hongos, alterando su capacidad de supervivencia. El uso adecuado de los antibióticos, ampliamente ignorado no solo en la acuicultura, sino también en el tratamiento de los seres humanos, implica aislar la bacteria responsable de un brote de enfermedad determinado. Aplicar el antibiótico equivocado para el problema específico con una dosis inadecuada, garantiza que las presiones de selección sobre la población bacteriana la conduzcan hacia la resistencia. Muchos acuicultores abusan de los antibióticos, aunque no todos lo hacen ni en todas partes.
Las bacterias son organismos complejos. Seguimos aprendiendo sobre su importancia para la salud y la enfermedad. Los estudios sugieren que existe una relación compleja entre el huésped y el microbioma
(el conjunto de bacterias presentes en un entorno determinado). Algunos creen que la composición específica del microbioma es lo que hace que los animales estén sanos; otros creen que esta composición no es la responsable de
la “buena” salud. Tales comunidades permiten a las bacterias actuar como grupos, que difieren de cómo actúan individualmente, conocidas como biopelículas. Las biopelículas son agregaciones de bacterias que están presentes en altas densida-

Algunos creen que la composición específica del microbioma es lo que hace que los animales estén sanos; otros creen que esta composición no es la responsable de la “buena” salud.

des y están protegidas de muchos impactos ambientales al estar en una biopelícula, incluidos algunos antibióticos y desinfectantes.
Los criadores de camarones suelen centrarse mucho en el papel de las especies de Vibrio en las enfermedades de estos crustáceos y… no es para menos. Este género de bacterias es omnipresente en los medios acuáticos marinos y de agua dulce, donde desempeñan un papel importante en el reciclaje de la quitina, un componente fundamental del caparazón de los camarones y de todos los demás crustáceos e insectos. La celulosa, un biopolímero presente en las plantas, es la más abundante y la quitina es el segundo. Hasta la fecha, se han identificado unas 150 especies de Vibrio, de las cuales tres especies son las responsables de la mayor parte del impacto en los seres humanos (Vibrio cholerae [amarillo en tiosulfato-citrato-sales biliaressacarosa, TCBS], V. parahaemolyticus [verde en TCBS] y V. vulnificus [verde azul en TCBS]), solo cepas específicas causan enfermedades. Muchas cepas son benignas porque no contienen las toxinas causantes de enfermedad. Esto puede deberse a la falta de los genes específicos, a la pérdida de la integridad del gen, a


la producción de un producto génico defectuoso, etc. Una docena de especies, también cepas específicas, causan enfermedades en camarones y peces, entre ellas se encuentran V. alginolyticus (color amarillo en TCBS), V. campbellii, V. parahaemolyticus y varias más. Algunos son patógenos obligados y otros son oportunistas. Los patógenos obligados suelen producir enfermedades agudas y puede bastar un nivel muy bajo de bacterias para iniciar el proceso en organismos sanos. Los patógenos oportunistas suelen requerir organismos debilitados, normalmente como resultado de otros procesos infecciosos, aunque existen muchos factores que pueden debilitarlos.
Cualquier población bacteriana se compone de muchas cepas diferentes. Las cepas que podemos cultivar no siempre son las causantes del impacto que intentamos correlacionar con la presencia de un proceso patológico específico. Las cepas varían en sus genes y en su expresión génica. Algunos géneros (como Vibrio) y especies (como V. parahaemolyticus) comparten suficientes rasgos como para considerarlos relacionados entre sí. Sin embargo, las cepas individuales dentro de una misma especie a menudo varían de manera impor-
tante. Esto provoca una gran confusión entre las personas no expertas. En el caso de los vibrios, esto ha dado lugar a diversos mitos muy extendidos. Quizá el que más daño hace, en última instancia, se basa en la capacidad de digerir la sacarosa, una molécula de azúcar compuesta por dos azúcares: glucosa y fructosa. Esta azúcar es abundante y está relacionada con diversos problemas de salud en los seres humanos. Cuando los vibrios utilizan la sacarosa como nutriente, producen ácidos orgánicos como subproducto. Estos cambian el pH y, en el medio selectivo y diferencial TCBS, dan lugar a colonias amarillas. Si no la consumen fácilmente, se ven colonias verdes. La capacidad de consumir la sacarosa no está relacionada con la capacidad de producir enfermedades. Centrarse en el cambio de color del amarillo al verde no va a eliminar la enfermedad por Vibrio. He escrito antes sobre este tema y sobre lo que se puede hacer para disminuir la incidencia y la gravedad de la enfermedad provocada por el Vibrio
Los antibióticos son sustancias químicas que interfieren en los procesos metabólicos de bacterias y hongos, alterando su capacidad de supervivencia. No son antivira-
Cualquier población bacteriana se compone de muchas cepas diferentes. Las cepas que podemos cultivar no siempre son las causantes del impacto que intentamos correlacionar con la presencia de un proceso patológico específico.
les (aunque hay algunos compuestos que tienen actividad antiviral y antibacteriana). Muchos de ellos han sido aprobados para su uso en humanos. En Estados Unidos, que también regula los antibióticos que pueden emplearse en productos importados, solo están autorizados unos pocos para usos muy específicos en acuicultura (https://www.fda. gov/animal-veterinary/aquaculture/ approved-aquaculture-drugs). Para obtener una explicación detallada sobre su funcionamiento, resistencia y otros aspectos, le sugerimos consultar el artículo de Saloni Dattani (2024), titulado “How do antibiotics work, and how does antibiotic resistance evolve?” (publicado en línea en OurWorldinData.org, https:// ourworldindata.org/how-do-antibiotics-work). Parece que se presta una atención desmesurada al abuso del uso de antibióticos en la acuicultura, a pesar de que la mayor parte del abuso se da en la terapia humana y en otros sectores de la agricultura. La acuicultura sigue siendo en gran medida una industria inmadura. El uso de antibióticos no es tan preocupante para el consumo interno como para la exportación. Gran parte de la producción mundial tiene lugar en países menos desarrollados, aunque hay algunas excepciones notables, como la cría de salmón, que se produce principalmente en Noruega y Chile. La producción de camarón de piscifactoría que en gran parte se destina a la exportación, tiene lugar en Ecuador, India, Vietnam, Indonesia y otros países. No existe un enfoque único y los paradigmas cambian constantemente. Las enfermedades son los principales obstáculos para lograr una producción sostenible. Muchas son de origen viral, con infecciones secundarias provocadas a menudo por vibrios. Las enfermedades primarias de origen bacteriano siguen siendo un reto. La mayoría de los patólogos especializados en acuicultura coinciden en que la causa principal de la muerte del camarón son las infecciones mixtas. El uso adecuado de los antibióticos, ampliamente ignorado no solo

en la acuicultura, sino también en el tratamiento de los seres humanos, implica aislar la bacteria responsable de un brote de enfermedad determinado. Si se trata de una nueva cepa o especie no declarada, debe existir una correlación científica clara entre su presencia y el proceso patológico observado. Las cepas aisladas se analizan mediante métodos estándar para determinar su sensibilidad a una serie de antibióticos. Esto determinará cuál es el antibiótico más eficaz. El antibiótico debe utilizarse en la dosis y durante el tiempo adecuados para garantizar una eficacia óptima. Para los acuicultores, el problema radica en el tiempo. Algunas enfermedades parecen propagarse muy rápidamente entre la población, por lo que el tiempo transcurrido entre la aparición de organismos moribundos (las aves pueden alertar a los acuicultores) y el abandono
del alimento es muy corto. Cunde el pánico y los acuicultores usan los antibióticos que tienen a mano, sin determinar si son adecuados. Al igual que en medicina humana, donde muchos de los antibióticos “más antiguos” son poco o nada eficaces, la tendencia es emplear los antibióticos más recientes y potentes. Aplicar el antibiótico equivocado para el problema específico con una dosis inadecuada, garantiza que las presiones de selección sobre la población bacteriana la conduzcan hacia la resistencia.
Aunque las biopelículas pueden proteger a las bacterias de la acción de una amplia gama de antibióticos, la resistencia a estos es natural. En Saloni Dattani (2024) se analizan los distintos mecanismos por medio de los cuales esto puede ocurrir. Todas las bacterias producen compuestos antimicrobianos. Se trata de un componente esencial de su capaci-

Los antibióticos pueden dejar residuos en la carne de los organismos tratados. Esta es una de las principales razones por las que los antibióticos deben someterse a pruebas y evaluaciones no solo por su eficacia contra organismos específicos, sino también por la capacidad de los animales en los que se usan para metabolizarlos.
dad para sobrevivir y desarrollarse en entornos con un gran número de bacterias que compiten por los nutrientes.
Los antibióticos pueden dejar residuos en la carne de los organismos tratados. Esta es una de las principales razones por las que estos deben someterse a pruebas y evaluaciones, no solo por su eficacia contra organismos específicos, sino también por la capacidad de los animales en los que se usan para metabolizarlos. Esto influye en las dosis, la duración del tratamiento y los tiempos de espera. Es decir, el tiempo necesario tras finalizar el tratamiento antibiótico para que los niveles de residuos metabólicos se sitúen por debajo de los umbrales legales. Solo se analizan de forma rutinaria unos pocos antibióticos y residuos específicos en los camarones de piscifactoría en el momento de la cosecha/procesamiento. La gran mayoría no. La mayoría de los antibióticos que se emplean en casos desesperados no son legales para su uso en animales acuáticos en los países a donde se exporta el producto final. Si los regulado-
res determinan que los residuos de estos antibióticos suponen un grave problema, la lista de antibióticos y metabolitos que se analizan podría ampliarse drásticamente. En general, cuando se exportan camarones tratados con antibióticos, es importante asegurarse de que el antibiótico específico empleado esté aprobado para su uso en el país de destino o, como mínimo, de que ha pasado el tiempo suficiente para garantizar que no queden residuos detectables.
El uso responsable de los antibióticos beneficia a todos. Garantiza que la resistencia se desarrolle más lentamente. En su mayor parte, la resistencia es inevitable debido a la propia naturaleza de las bacterias. Incluso la tolerancia es problemática, ya que se necesitan dosis más altas para obtener el efecto deseado. Muchos acuicultores abusan de los antibióticos, aunque no todos lo hacen ni en todas partes.
El término sostenibilidad se ha convertido en una frase de marketing carente de significado. En el ámbito de la acuicultura, significa ser capaz de obtener un producto
de manera económica sin impactar negativamente en el entorno de producción. Esto incluye la gestión de residuos y los programas progresivos de prevención y mitigación de enfermedades. Disponer de antibióticos eficaces y usarlos de forma responsable es un componente esencial de este proceso.
* Stephen G. Newman es licenciado en Conservación y Gestión de Recursos (ecología) por la Universidad de Maryland y doctor en Microbiología Marina por la Universidad de Miami. Tiene más de 40 años de experiencia trabajando en diversos temas y enfoques de la acuicultura, como la calidad del agua, la sanidad animal y la bioseguridad, con especial atención al camarón y los salmónidos. Fundó Aquaintech Inc. en 1996 y sigue siendo su director general. Se centra en la prestación de servicios de consultoría sobre tecnologías microbianas y bioseguridad en todo el mundo. sgnewm@aqua-in-tech.com www.aqua-in-tech.com www.bioremediationaquaculture.com www.sustainablegreenaquaculture.com

ALIMENTOS BALANCEADOS
CARGILL........................5, SEGUNDA DE FORROS, CONTRAPORTADA
Carretera Internacional y Calle Fresno S/N Parque
Industrial No. 2
C.P. 85000 | Cd. Obregón, Sonora.
Contacto: Osvaldo Anaya / Clarissa Navarro
Tel: 644 410 6235
E-mail: clarissa_navarro@cargill.com www.cargill.com.mx
MEGASUPPLY
Centroamérica, EE.UU., Europa, Sudamérica, Asia y Medio Oriente
Tel: +1 305 381 0210
E-mail: orders@megasupply.net
W: www.megasupply.net
NATIONAL RENDERERS ASSOCIATION, INC…
Oficina para Latinoamérica: Sierra Candela 111 Oficina 501. Lomas de Chapultepec
C.P. 11000 CDMX
Contacto: Luz María Cano
Tel: (55) 55 5980 6080
E-mail: nramex@nralatinamerica.org
21
E: thais@thaiscorp.com
W: www.thaiscorp.com/expopesca
AQUACULTURE AMERICA 2025..... .....................37
Mar. 6-10, 2025
New Orleans, EE.UU. E: worldaqua@was.org W: www.was.org
AQUACULTURE EUROPE 2025 ...1
Sept. 22-25, 2025
Valencia, España E: worldaqua@was.org W: www.aquaeas.org
AQUAFUTURE SPAIN 2025...........................................46
May. 20-25, 2025
VIGO, España
T: +34620681861
27
W: https://www.aquafuturespain.com
LACQUA 2025 .39
Oct. 6-9, 2025
Hotel Enjoy, Puerto Varas, Chile E: carolina@was.org W: www.was.org.
ZEIGLER BROS, INC...........TERCERA DE FORROS
400 Gardners, Station RD, Gardners, PA. 17324, EE.UU. Contacto: Susan Thompson Tel: 717 677 6181
E-mail: sales@zeiglerfeed.com www.zeiglerfeed.com
ANTIBIÓTICOS, PROBIÓTICOS Y ADITIVOS PARA ALIMENTOS
MEGASUPPLY 21
Centroamérica, EE.UU., Europa, Sudamérica, Asia y Medio Oriente
Tel: +1 305 381 0210
E-mail: orders@megasupply.net
W: www.megasupply.net
PRILABSA INTERNATIONAL CORP 11 2970 W. 84 St. Bay #1, Hialeah, FL. 33018, EE.UU.
Contacto: Roberto Ribas.
Tel: 305 822 8201, 305 822 8211
E-mail: rribas@prilabsa.com www.prilabsa.com
EQUIPOS DE AIREACIÓN, BOMBEO, FILTROS, MOBILIARIO PARA LABORATORIO E INSTRUMENTOS DE MEDICIÓN
SUN ASIA AERATION INT´L Co., Ltd......................9 15f, 7, Ssu-wei 4 road, Ling-ya District, Kaohsiung, 82047 Táiwan R.O.C.
Contacto: Ema Ma.
Tel: 886 7537 0017, 886 7537 0016
E-mail: sales@pioneer.tw.com www.pioneer-tw.com
EVENTOS Y EXPOSICIONES
11VA. FERIA INTERNACIONAL DE EQUIPOS Y SERVICIOS PARA PESCA & ACUICULTURA (EXPOPESCA - ACUIPERÚ)/3RA. FERIA INTERNACIONAL DE PESCADOS, MARISCOS & DERIVADOS (SEAFOOD LIMA) 33
Sept. 3-5, 2025
Lima, Perú T: +51 989-177-352
Panorama Acuícola Magazine
Empresarios No. #135 Int. Piso 7 Oficina 723
Col. Puerta de Hierro, C.P.45116. Zapopan, Jal. México. Cruza con las calles Av. Paseo Royal Country y Blvrd. Puerta de Hierro
Tels: +52 (33) 8000 0578
Contacto 1: Suscripciones
E-mail: suscripciones@panoramaacuicola.com
Tel: +52 (33) 8000 0629 y (33) 8000 0653
Contacto 2: Juan Carlos Elizalde, ventas y mercadotecnia
E-mail: crm@dpinternationalinc.com www.panoramaacuicola.com

Aquaculture Magazine
Design Publications International Inc.
203 S. St. Mary’s St. Ste. 160
San Antonio, TX 78205, EE.UU.
Oficina en EE.UU: +(210) 229 9036
Oficina en EE.UU, Directo: +(210) 504 3642
Oficina en México: (+52) (33) 3632 2355
Suscripciones: iwantasubscription@dpinternationalinc.com
Publicidad: crm@dpinternationalinc.com / sse@dpinternationalinc.com www.aquaculturemag.com
SIMEC AQUAFISH
Feb. 3-5, 2025
Riyad, Arabia Saudita
T: +966 506467847
E: exhibition@cityevents.com.sa
W: https://en.simec-expo.com
AQUACULTURE 2025
Marzo 6-10, 2025
New Orleans, EE.UU.
T: (+1) 760 751 5005
Fax: (+1) 760 751 5003
E: worldaqua@was.org
W: www.was.org, www.shellfish.org, fishculture.fisheries.org, www.nationalaquaculture.org
AQUAEXPO SANTA ELENA 2025
Marzo 12-13, 2025
Santa Elena, Ecuador
T: +593 99 377 1572
E: aquaexpoec@cna-ecuador.com
W: https://www.aquaexpo.com.ec/
AQUASUR TECH 2025
Marzo 26-27, 2025
Punta Arenas, Chile
T: +56 2 2530 7209
E: kfarfan@fisa.cl
W: https://www.aquasurtech.cl
BLUE FOOD INNOVATION SUMMIT 2025
Abril 8-9, 2025
Londres, Reino Unido
T: +44 (0)1273 789989
E: info@rethinkevents.com
W: www.bluefoodinnovation.com
3era. CONFERENCIA Y EXPOSICIÓN INTERNACIONAL SOBRE ACUICULTURA Y PESCA (AQUACULTURE HORIZONS 2025)
Abril 28-30, 2025
Lisboa, Portugal
T: +61 390163202
E: sillas@europeaquacultureconference.com
W: https://www.europeaquacultureconference. com/
AQUACULTURE SPAIN
Mayo 20-22, 2025
Vigo, España
T: +34620681861
W: https://www.aquafuturespain.com
WORLD AQUACULTURE SAFARI 2025
Junio 24-27, 2025
Entebbe, Uganda
T: +34620681861
W: https://www.was.org
AQUAEXPO EL ORO 2025
Julio 20-23, 2025
Machala, Ecuador
T: +593 99 377 1572
E: aquaexpoec@cna-ecuador.com
W: https://www.aquaexpo.com.ec/
AQUA NOR
Ago. 19-21, 2025
Trondhein, Noruega
T: +47 73 56 86 40
E: post@nor-fishing.no
W: https://www.aquanor.no/en/
11va. FERIA INTERNACIONAL DE EQUIPOS Y SERVICIOS PARA PESCA & ACUICULTURA/3era. FERIA INTERNACIONAL DE PESCADOS, MARISCOS & DERIVADOS
Sept. 03-05, 2025
Lima, Perú
W: +51 989 177 352
E: thais@thaiscorp.com
W: www.thaiscorp.com/expopesca/
VICTAM LATAM
Sept. 16-18, 2025
Sao Paulo, Brasil
T: +31 33 246 4404
E: expo@victam.com
W: https://www.allaquaculture.com/events/ victam-latam-2025/
AQUACULTURE EUROPE 2025
Sept. 22-25, 2025
Valencia, España
T: (+1) 760 751 5005
E: worldaqua@was.org
W: www.was.org, www.aquaeas.org
24va. RESPONSIBLE SEAFOOD SUMMIT
Sept. 29, 2025
Cartagena, Colombia
W: https://events.globalseafood.org/responsible-seafood-summit
LAQUA 2025
Oct. 6-9, 2025
Puerto Varas, Chile
T: (+1) 760 751 5005
Fax: (+1) 760 751 5003
E: worldaqua@was.org
W: www.was.org
AQUAEXPO GUAYAQUIL 2025
Oct. 20-23, 2025
Guayaquil, Ecuador
T: +593 99 377 1572
E: aquaexpoec@cna-ecuador.com
W: https://www.aquaexpo.com.ec/






+ Biodisponibilidad Proceso en frío para preservar ingredientes sensibles
+ Digestibilidad y densidad de nutrientes mejorado Tasas de conversión mejoradas



+ Nutrición equilibrada Mayor absorción de lípidos